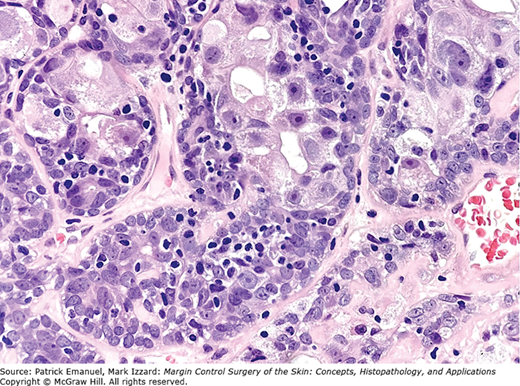

Dermatology Question of the Week: Deductive Dermpath

A 68-year-old man presents with a slow-growing violaceous nodule on the scalp. The lesion is asymptomatic and has been present for several months. Excisional biopsy reveals a well-circumscribed dermal and subcutaneous neoplasm composed of lobules of basaloid cells with peripheral palisading and central areas of necrosis. Mitotic figures are frequent. The tumor is surrounded by a thick eosinophilic basement membrane–like material. On immunohistochemistry, the tumor is positive for EMA and cytokeratins, but negative for Ber-EP4. A representative image is shown below.
Which of the following is the most likely diagnosis?
A. Basal cell carcinoma
B. Trichoepithelioma
C. Merkel cell carcinoma
D. Adnexal carcinoma (specifically: eccrine porocarcinoma)
E. Spiradenocarcinoma
Rationale:
This question tests the recognition of malignant transformation of an adnexal tumor, and the ability to distinguish it from common mimickers like basal cell carcinoma (BCC) or Merkel cell carcinoma (MCC).
Correct answer: E. Spiradenocarcinoma
Spiradenocarcinoma is the malignant counterpart of spiradenoma and is composed of basaloid lobules with nuclear atypia, increased mitotic activity, and areas of necrosis. It retains features of benign spiradenoma, such as dual-cell population and eosinophilic basement membrane–like material and often shows abrupt transition from benign to malignant areas. Tumors are EMA-positive, CK-positive, and Ber-EP4–negative, helping to distinguish from BCC.
Incorrect answers:
A. Basal cell carcinoma can have palisading and basaloid cells, but usually lacks eosinophilic basement membrane material and shows Ber-EP4 positivity. They are typically not EMA positive.

B. Trichoepithelioma is a benign follicular tumor with basaloid cells, but shows horn cysts and papillary mesenchymal bodies, and lacks significant mitotic activity or necrosis.

C. Merkel cell carcinoma is a neuroendocrine tumor which shows small blue cell morphology, high mitotic rate, and is positive for CK20 in a dot-like pattern and neuroendocrine markers (e.g., chromogranin, synaptophysin). It is not typically associated with basement membrane–like material.

D. Eccrine porocarcinoma may show ductal differentiation and clear cytoplasm, but lacks the thick eosinophilic basement membrane–like material seen in spiradenocarcinoma. It often shows infiltrative growth with prominent ductal structures.

Additional reading at Fitpatrick's Dermatology Chapter 109: Appendage Tumors of the Skin

Create a Free MyAccess Profile
AccessMedicine Network is the place to keep up on new releases for the Access products, get short form didactic content, read up on practice impacting highlights, and watch video featuring authors of your favorite books in medicine. Create a MyAccess profile and follow our contributors to stay informed via email updates.